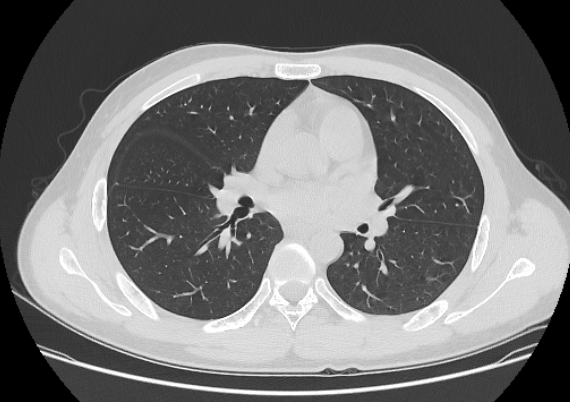
AI Case

CT Lung
CT Lung CTA
CTA MRI Brain
MRI Brain X-Ray
X-Ray
AI驱动的医学影像教学新时代
AI赋能医学影像教学
AI赋能医学影像教学
培养卓越诊疗人才
汇聚海量真实病例,融合AI智能诊断技术,为医学影像教学提供全新的互动学习体验
 CT Abdomen
CT Abdomen MRI Spine
MRI Spine AI Case
AI Case Platform
Platform
智能影像案例训练
海量真实病例库
海量真实病例库
AI辅助诊断训练
2000+精选影像病例,涵盖全身各系统,支持AI辅助诊断推理与学习路径规划
 Dashboard
Dashboard Analytics
Analytics CT Lung
CT Lung MRI Brain
MRI Brain
医教研一体化
医教研深度融合
医教研深度融合
打造教学新生态
整合临床、教学、科研资源,构建全方位的医学影像数字化教学平台

